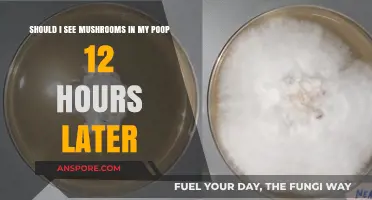
Mushrooms in Poop: Should You See Them 12 Hours Later?

When deciding whether to sauté mushrooms for quiche, it’s essential to consider both flavor and texture. Sautéing mushrooms removes excess moisture, preventing a soggy quiche, while enhancing their earthy flavor through caramelization. This step also concentrates their umami richness, adding depth to the dish. However, if time is a constraint, raw mushrooms can be used, though they may release more liquid during baking. Ultimately, sautéing mushrooms is a worthwhile step for a more flavorful and structurally sound quiche, especially if you’re aiming for a professional finish.
| Characteristics | Values |
|---|---|
| Enhances Flavor | Sautéing mushrooms deepens their flavor through caramelization, adding richness to the quiche. |
| Reduces Moisture | Sautéing removes excess water from mushrooms, preventing a soggy quiche crust. |
| Improves Texture | Cooked mushrooms have a firmer texture compared to raw, which holds up better in baking. |
| Time Investment | Adds an extra step and time to the quiche preparation process. |
| Optional Step | Not strictly necessary; raw mushrooms can be used, but sautéing is recommended for better results. |
| Seasoning Opportunity | Allows for seasoning mushrooms with salt, pepper, garlic, or herbs before adding to the quiche. |
| Aesthetic Appeal | Sautéed mushrooms may have a more appealing browned color in the final dish. |
| Fat Addition | Requires oil or butter for sautéing, slightly increasing the overall fat content of the quiche. |
| Flavor Intensity | Sautéed mushrooms provide a more intense, umami flavor compared to raw mushrooms. |
| Consistency | Ensures mushrooms are evenly cooked and distributed throughout the quiche. |
Explore related products
What You'll Learn
- Sautéing vs. Raw Mushrooms: Enhances flavor, reduces moisture, prevents sogginess in quiche filling
- Best Mushroom Types: Button, cremini, shiitake, or portobello for texture and taste
- Cooking Time: Sauté until golden, 5-7 minutes, to release umami
- Seasoning Tips: Add garlic, thyme, or butter for extra depth
- Cool Before Adding: Prevent curdling eggs; let mushrooms cool before mixing into quiche

Sautéing vs. Raw Mushrooms: Enhances flavor, reduces moisture, prevents sogginess in quiche filling
When deciding whether to sauté mushrooms for quiche, the primary consideration should be how this step impacts flavor, moisture, and texture. Sautéing mushrooms enhances their flavor significantly by concentrating their natural umami richness. Raw mushrooms, while edible, have a milder taste that can get lost in the quiche filling. By cooking them in butter or oil over medium heat until golden brown, you unlock deeper, more complex flavors that complement eggs, cheese, and other ingredients in the quiche. This extra step ensures the mushrooms contribute a robust, savory element to the dish rather than blending into the background.
Another critical benefit of sautéing mushrooms is moisture reduction, which directly prevents sogginess in the quiche filling. Raw mushrooms release a considerable amount of water when baked, which can dilute the custard base and create a wet, unappealing texture. Sautéing evaporates this excess moisture, leaving the mushrooms tender but not waterlogged. This process also helps the mushrooms better integrate with the egg mixture, ensuring a cohesive and well-set filling. For a quiche with a clean, dry slice, sautéing is the more reliable choice.
Sautéing mushrooms also gives you control over their texture, ensuring they don’t remain rubbery or undercooked in the final dish. Raw mushrooms can sometimes retain a chewy consistency when baked in a quiche, especially if they’re thickly sliced. Sautéing softens them to the ideal tenderness, creating a harmonious mouthfeel alongside the creamy custard and flaky crust. This step is particularly important if you’re using heartier mushroom varieties like portobellos or cremini, which benefit from pre-cooking.
While sautéing mushrooms requires an extra step, the payoff in flavor and texture is well worth the effort. If you’re short on time, using raw mushrooms isn’t a dealbreaker, but be prepared for a milder flavor and a higher risk of moisture issues. To mitigate this, you can lightly salt raw mushrooms to draw out excess water before adding them to the quiche, but this won’t yield the same depth of flavor as sautéing. For the best results, especially in a dish as nuanced as quiche, sautéing mushrooms is the recommended approach.
In summary, sautéing mushrooms for quiche enhances their flavor, reduces moisture, and prevents sogginess in the filling. This method ensures the mushrooms contribute a rich, savory quality to the dish while maintaining the ideal texture and consistency. While raw mushrooms can work in a pinch, sautéing is the superior choice for a professional, well-balanced quiche. The extra time spent at the stove will elevate the entire dish, making it a worthwhile step for any quiche enthusiast.
Unlocking the Secret to Perfectly Carmelized Mushrooms
You may want to see also

Best Mushroom Types: Button, cremini, shiitake, or portobello for texture and taste
When deciding whether to sauté mushrooms for quiche, selecting the right mushroom type is crucial for achieving the desired texture and flavor. Button mushrooms, the most common variety, are mild and versatile, making them an excellent choice for quiche. Their firm texture holds up well during sautéing, ensuring they don’t become mushy in the egg mixture. However, their mild flavor means they benefit from being cooked with aromatic ingredients like garlic, thyme, or shallots to enhance their taste in the quiche.
Cremini mushrooms, often called baby portobellos, offer a slightly earthier and nuttier flavor compared to button mushrooms. Their denser texture makes them ideal for sautéing, as they retain their structure and add a hearty bite to the quiche. Cremini mushrooms are a great middle ground for those who want more flavor than button mushrooms but prefer something less intense than shiitake or portobello. Sautéing them until golden brown will deepen their flavor and complement the creamy egg base of the quiche.
For a more robust and umami-rich profile, shiitake mushrooms are an excellent choice. Their meaty texture and rich, savory flavor can elevate a quiche, especially when paired with cheeses like Gruyère or goat cheese. However, shiitakes have a chewier texture, so they must be sautéed thoroughly to soften them and release their full flavor. Removing the tough stems before cooking is also recommended to ensure a pleasant bite in every slice of quiche.
Portobello mushrooms, with their large caps and meaty texture, can be a bold choice for quiche. While they offer a deep, earthy flavor, their size and texture require careful preparation. Slice them thinly before sautéing to ensure they cook evenly and integrate well into the quiche. Portobellos are best for those who want a mushroom-forward quiche with a substantial, almost steak-like bite. However, their strong flavor may overpower more delicate ingredients, so balance is key.
In summary, the best mushroom type for your quiche depends on the texture and flavor you’re aiming for. Button mushrooms are mild and reliable, cremini mushrooms add a nutty depth, shiitakes bring umami richness, and portobellos offer a meaty, bold experience. Regardless of your choice, sautéing the mushrooms is essential to remove excess moisture and concentrate their flavors, ensuring they enhance rather than weigh down your quiche.
Ryze Mushroom Coffee: Coffee or Not?
You may want to see also

Cooking Time: Sauté until golden, 5-7 minutes, to release umami
When preparing mushrooms for a quiche, sautéing them is a crucial step that enhances their flavor and texture. The Cooking Time: Sauté until golden, 5-7 minutes, to release umami is a key guideline to follow. This process not only softens the mushrooms but also unlocks their deep, savory umami flavor, which adds complexity to your quiche. Start by heating a tablespoon of butter or olive oil in a skillet over medium heat. Once the fat is hot but not smoking, add your sliced or chopped mushrooms in a single layer, ensuring they have enough space to cook evenly. Overcrowding the pan can cause them to steam instead of sauté, so cook in batches if necessary.
During the 5-7 minute sauté, you’ll notice the mushrooms begin to release their moisture and then reabsorb it, leading to a golden-brown color. This browning is essential, as it develops the umami flavor through the Maillard reaction, a chemical process that creates rich, savory notes. Stir the mushrooms occasionally to ensure even cooking, but avoid stirring too frequently, as this can prevent them from caramelizing properly. The transformation from pale and raw to golden and tender should take no longer than 7 minutes, depending on the heat and the type of mushroom used.
It’s important to season the mushrooms during this step. Add a pinch of salt and pepper to enhance their natural flavors. Some cooks also like to add minced garlic or fresh herbs like thyme toward the end of the sauté to complement the earthy taste of the mushrooms. However, be mindful of timing—garlic burns quickly, so add it in the last minute or two of cooking. The goal is to achieve perfectly sautéed mushrooms that are tender, golden, and packed with umami, ready to elevate your quiche filling.
After 5-7 minutes, the mushrooms should be ready. You’ll know they’re done when they’re golden brown, slightly softened, and fragrant. At this point, remove them from the heat to prevent overcooking, which can make them rubbery or mushy. Let them cool slightly before incorporating them into your quiche mixture. This brief resting period allows any excess moisture to evaporate, ensuring your quiche filling isn’t watery.
By adhering to the Cooking Time: Sauté until golden, 5-7 minutes, to release umami, you’ll ensure your mushrooms contribute a rich, savory flavor and pleasing texture to your quiche. This simple yet impactful step makes a noticeable difference in the final dish, turning ordinary mushrooms into a standout ingredient. Whether you’re using button, cremini, or wild mushrooms, this technique is versatile and foolproof, making it a must-do for any quiche recipe featuring mushrooms.
Mushroom Storage: Fridge or Shelf?
You may want to see also
Explore related products

Seasoning Tips: Add garlic, thyme, or butter for extra depth
When sautéing mushrooms for quiche, incorporating garlic is a game-changer for adding depth and complexity. Start by mincing or finely chopping fresh garlic cloves and adding them to the pan after the mushrooms have released most of their moisture. This ensures the garlic cooks gently without burning, infusing its aromatic flavor into the mushrooms. Garlic complements the earthy taste of mushrooms, creating a rich base for your quiche. For a milder garlic flavor, sauté it for a few minutes until fragrant; for a bolder taste, let it cook slightly longer to deepen its richness. This simple addition elevates the overall flavor profile of your quiche filling.
Thyme is another essential seasoning that pairs beautifully with sautéed mushrooms in quiche. Its herbal, slightly woody notes enhance the mushrooms' natural earthiness. Add fresh thyme sprigs directly to the pan while sautéing, allowing the heat to release their essential oils. If using dried thyme, sprinkle it over the mushrooms toward the end of cooking to avoid over-drying. Thyme not only adds depth but also brings a subtle sophistication to the dish. Its flavor melds seamlessly with eggs and cheese in the quiche, creating a harmonious and well-rounded taste.
Incorporating butter into the sautéing process is a luxurious way to add depth and richness to your mushrooms. Use butter as your primary cooking fat or add a tablespoon toward the end of sautéing for a finishing touch. Butter's creamy, nutty flavor enhances the mushrooms' umami qualities, making them more decadent. As the butter melts and coats the mushrooms, it creates a velvety texture that translates into a smoother, more indulgent quiche filling. Be mindful not to burn the butter—keep the heat moderate to preserve its flavor.
Combining garlic, thyme, and butter together takes your sautéed mushrooms to the next level. Start by melting butter in the pan, then add garlic and thyme to create a fragrant base before adding the mushrooms. This trio of ingredients works synergistically, with butter amplifying the flavors of garlic and thyme while the herbs and garlic enhance the mushrooms' natural taste. The result is a deeply flavorful foundation for your quiche that stands out even when paired with other ingredients like cheese or vegetables.
For maximum flavor impact, consider finishing the sautéed mushrooms with a final touch of these seasonings. After cooking, remove the pan from the heat and stir in a small amount of fresh garlic, a sprinkle of thyme, or a knob of butter. This technique ensures the ingredients retain their vibrant flavors without being muted by prolonged cooking. Such a finishing step adds a layer of freshness and richness that carries through every bite of your quiche, making it memorable and delicious.
Mushrooms: Freshness and Perishability Explored
You may want to see also

Cool Before Adding: Prevent curdling eggs; let mushrooms cool before mixing into quiche
When preparing mushrooms for a quiche, sautéing them is a popular method to enhance their flavor and remove excess moisture. However, it’s crucial to let the sautéed mushrooms cool before adding them to the egg mixture. This step is essential to prevent the eggs from curdling, which can result in a grainy or uneven texture in your quiche. Eggs are sensitive to heat, and mixing them with hot mushrooms can cause the proteins to cook prematurely, leading to curdling. By allowing the mushrooms to cool to room temperature, you ensure that the eggs remain stable and create a smooth, creamy custard.
The process of cooling sautéed mushrooms before incorporating them into the quiche is straightforward but requires a bit of patience. After sautéing the mushrooms until they are golden brown and their moisture has evaporated, transfer them to a plate or bowl and let them sit for at least 10–15 minutes. This cooling period allows the mushrooms to release any remaining steam and reach a temperature that won’t affect the eggs. If you’re short on time, you can spread the mushrooms on a larger surface area or place them in the refrigerator for a few minutes to expedite cooling, but avoid rushing this step.
Another reason to cool the mushrooms is to prevent the quiche crust from becoming soggy. Hot mushrooms can release moisture into the egg mixture, which may seep into the crust during baking, resulting in a less-than-ideal texture. By cooling the mushrooms, you minimize this risk and ensure that the crust remains crisp and flaky. Additionally, cooled mushrooms are easier to distribute evenly throughout the quiche filling, ensuring every bite is flavorful and well-balanced.
Incorporating cooled mushrooms into the quiche is simple once they’ve reached room temperature. Sprinkle them over the cheese layer in your pie crust, then gently pour the egg mixture on top. This method ensures the mushrooms are evenly distributed without sinking to the bottom. It also allows the flavors of the mushrooms to meld seamlessly with the eggs and cheese during baking. Taking the time to cool the mushrooms properly is a small but impactful step that elevates the overall quality of your quiche.
Finally, cooling sautéed mushrooms before adding them to your quiche is a best practice that addresses both texture and flavor. It prevents egg curdling, protects the crust from sogginess, and ensures even distribution of ingredients. While it may seem like an extra step, it’s one that significantly contributes to the success of your dish. By following this guideline, you’ll achieve a quiche with a silky custard, a perfectly cooked crust, and a harmonious blend of flavors that will impress your guests or satisfy your own culinary standards.
Mushroom Legality: Federal Law and Fungi
You may want to see also
Frequently asked questions
Yes, sautéing mushrooms before adding them to a quiche is recommended. Sautéing removes excess moisture, concentrates their flavor, and prevents the quiche from becoming soggy.
Sauté mushrooms over medium heat for about 5–7 minutes, or until they are golden brown and their liquid has evaporated. This ensures they are fully cooked and flavorful.
While you can skip sautéing, raw mushrooms may release excess moisture into the quiche, making it watery. Sautéing is a quick step that significantly improves texture and taste.